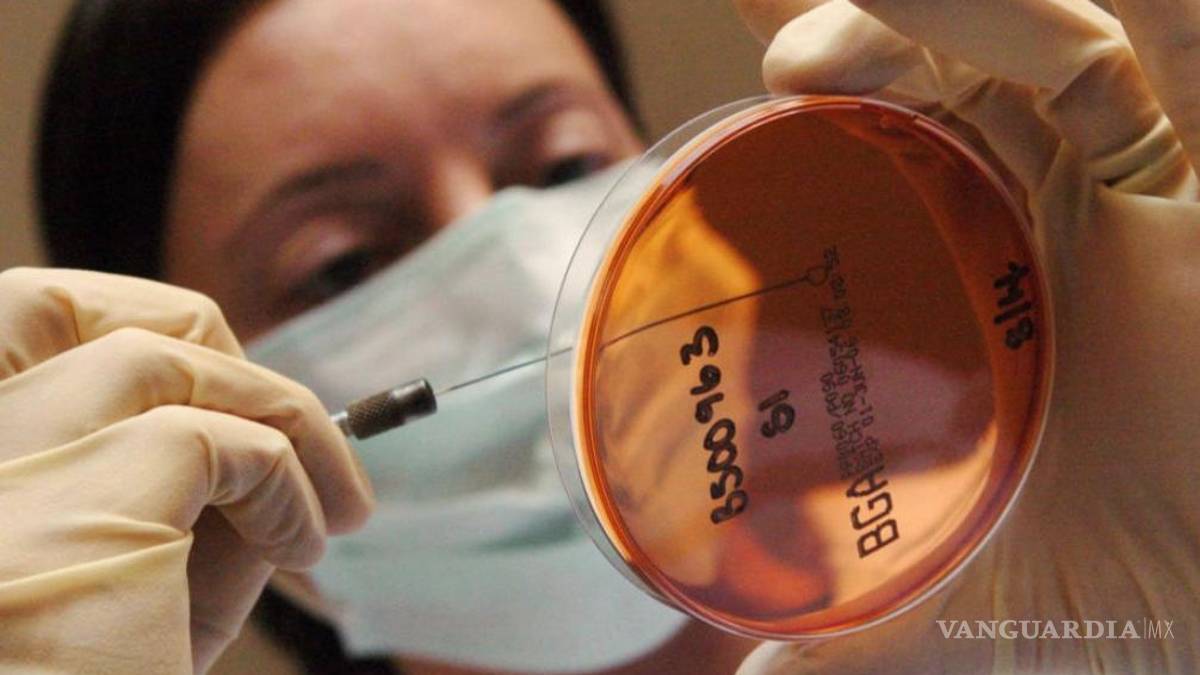

Estos son los síntomas de la salmonella, bacteria presente en algunos chocolates Kinder
Los alimentos que comúnmente suelen contaminarse con salmonella son de origen animal como res, pollo, leche y huevos
Luego de los brotes de salmonella en diferentes partes del mundo debido a huevos Kinder contaminados con esa bacteria, entre ellos Estados Unidos y México, la salmonella se ha convertido en un tema de interés
De acuerdo con los Centros para el Control y la Prevención de Enfermedades (CDC) la salmonella es una bacteria que puede causar una fuerte infección causada por un microbio que se encuentra en el tracto intestinal de animales.
TE PUEDE INTERESAR: Alertan en México por chocolates ‘Kinder mini eggs’ contaminados con salmonella
Los alimentos que comúnmente suelen contaminarse con salmonella son de origen animal como res, pollo, leche y huevos. Sin embargo, otros alimentos como las frutas, vegetales y productos procesados no quedan exentos de ser contaminados por esta bacteria.
Otras formas de contraer salmonella es a través del consumo de agua contaminada, o mascotas que podrían tener contacto con zoológicos interactivos, granjas, ferias y escuelas.
¿Cómo detectar la salmonella?
Los síntomas por salmonella suelen ser graves, pueden comenzar de 6 horas a 6 días tras la infección:
Diarrea (en el peor de los casos con sangre)
Fiebre
Cólicos estomacales
Vómitos prolongados que no permiten mantener los líquidos en el cuerpo
Deshidratación (boca y garganta seca) Producción escasa de orina
Mareos
La mayoría de las personas infectadas con salmonella suelen recuperarse en 4 a 7 días sin tomar algún antibiótico.
¿Cómo prevenir la salmonella?
Limpiar: Es importante lavarse las manos antes y después de manipular alimentos como carne, pollo, pescado y huevos crudos, poco cocidos o en su jugo. Lavar los utensilios como tablas de cortar, platos y cuchillos. Y por último, limpiar todos las superficies de la cocina para evitar la propagación de microbios.
Separar: Usar tablas diferentes para cortar las frutas y verduras de las carnes. También es importante separar todos los alimentos de origen animal durante las compras en el supermercado y dentro del refrigerador.
Cocinar: La cocción correcta de las carnes evitará las infecciones de salmonella en casa, esto incluye los huevos, no consuma huevos crudos ni huevos con claras o yemas de consistencia líquida.








